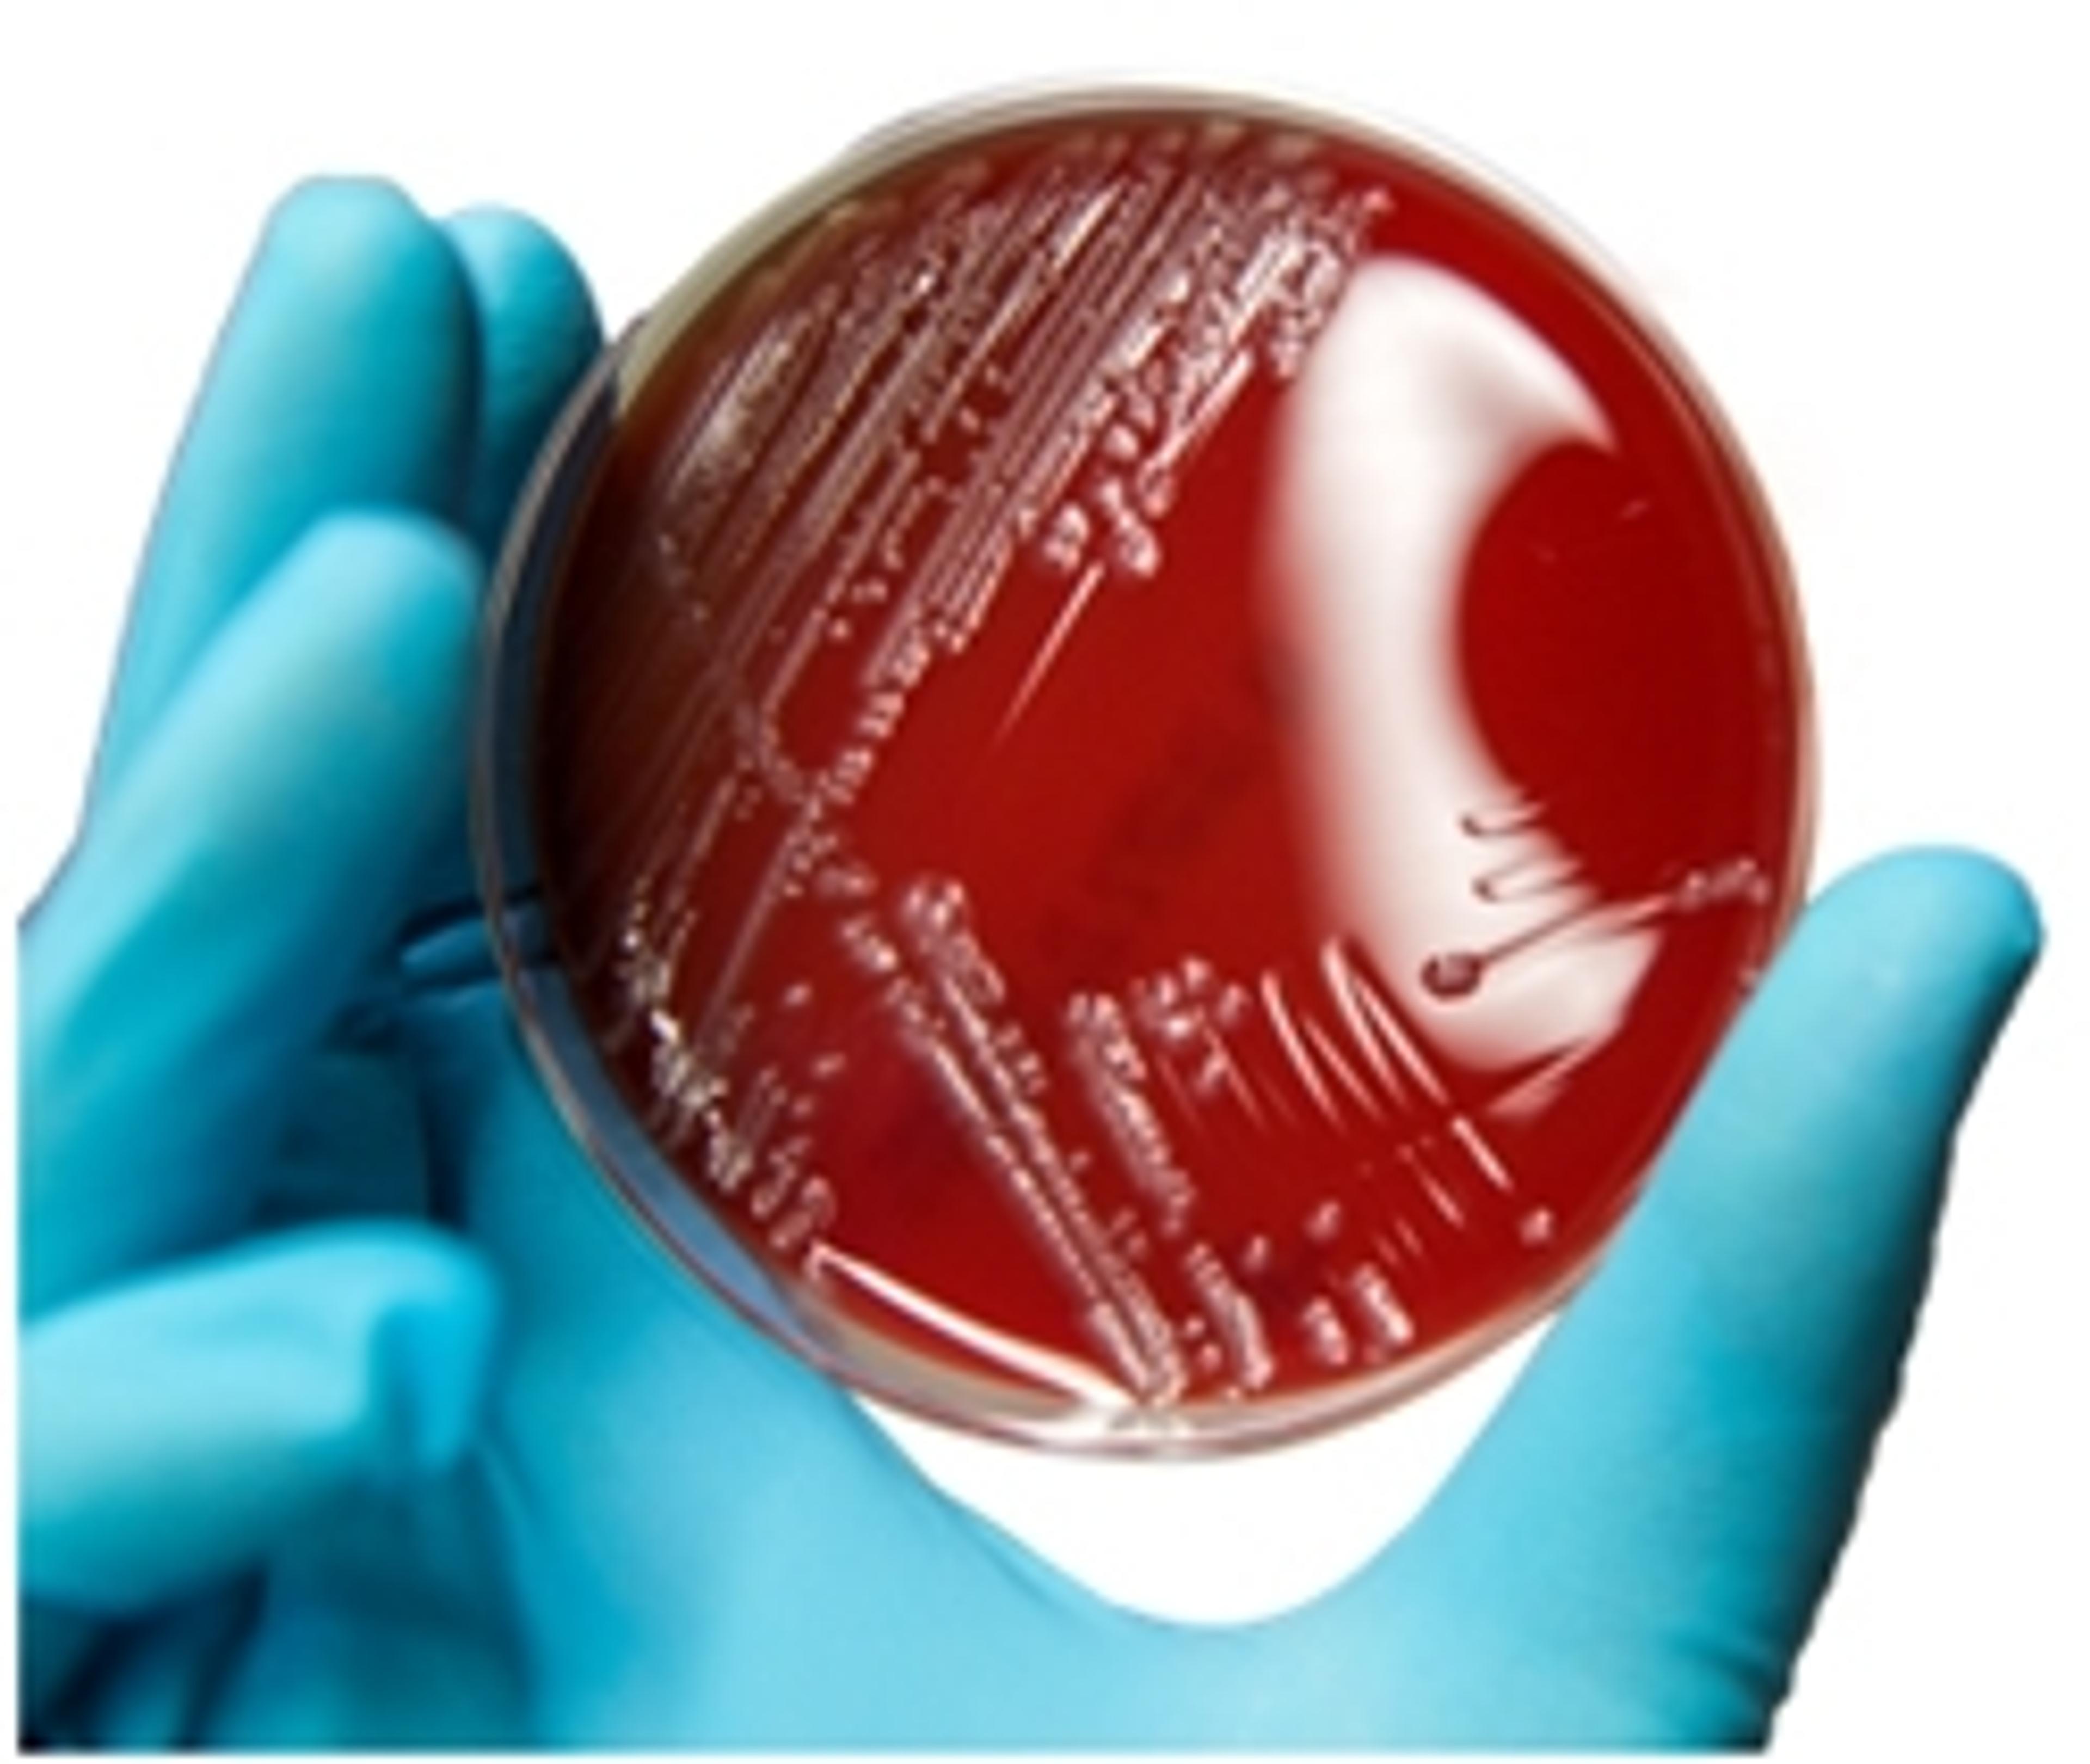

Bruker showcases kit‑enabled and chromatography‑free workflows at MSACL
Partnerships with PinPoint Testing LLC, RECIPE Chemicals + Instruments GmbH and biocrates life sciences ag highlight assays and turnkey DART MS/MS solutions on the EVOQ® DART-TQ⁺